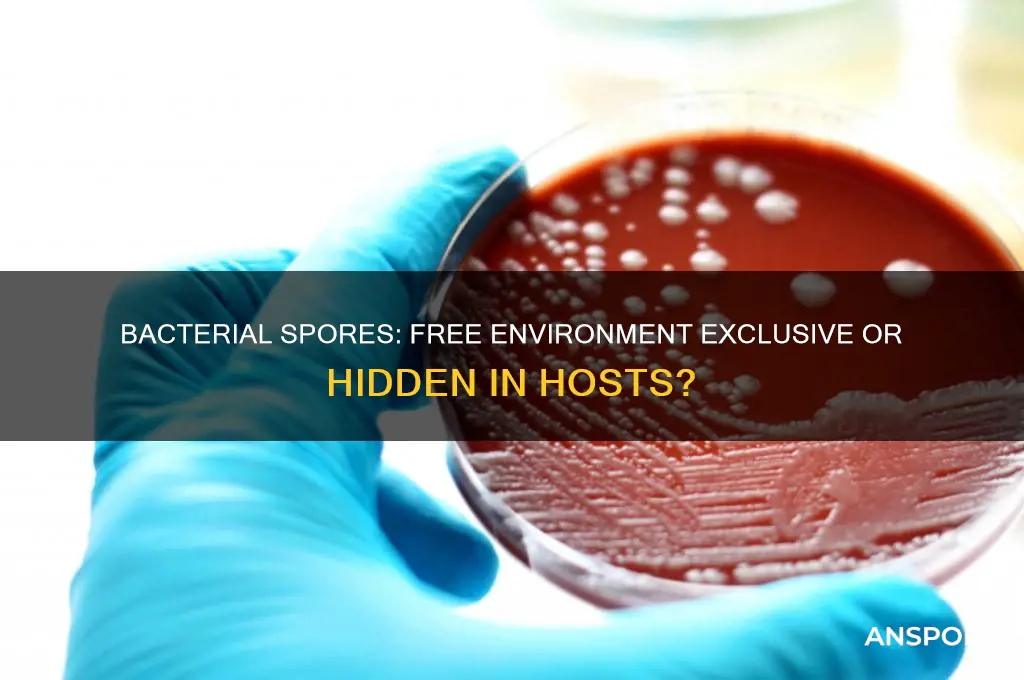
do bacterial spores exist only in free environment

Bacterial spores are highly resistant, dormant structures produced by certain bacteria as a survival mechanism in adverse environmental conditions. While they are commonly associated with free environments such as soil, water, and air, where they can persist for extended periods, their existence is not limited to these settings. Bacterial spores can also be found in association with living organisms, including plants, animals, and humans, either as part of their natural microbiota or as contaminants. Additionally, spores can survive in clinical and industrial settings, posing challenges in sterilization and infection control. Therefore, while free environments are primary reservoirs, bacterial spores are not exclusively confined to them, highlighting their adaptability and widespread presence across diverse ecosystems.
| Characteristics | Values |
|---|---|
| Existence in Free Environment | Bacterial spores can exist in free environments, such as soil, water, and air, where they can remain dormant for extended periods. |
| Intracellular Existence | Bacterial spores are primarily formed within the bacterial cell (endospores) and are not typically found free-floating in the environment until the cell lyses or is disrupted. |
| Survival in Host Organisms | Some bacterial spores can survive within host organisms (e.g., animals, plants) but are not exclusively found there; they are often released into the environment upon host death or excretion. |
| Dormancy and Resistance | Spores are highly resistant to harsh conditions (heat, desiccation, chemicals) and can remain dormant in both free environments and within host remains. |
| Exclusivity to Free Environment | Bacterial spores are not exclusive to free environments; they can exist in association with living or dead organisms but are most commonly encountered in soil and other natural habitats. |
| Formation Location | Spores are formed within the bacterial cell and are released into the environment upon cell lysis, not exclusively formed in free environments. |
| Ecological Role | Spores serve as a survival mechanism in free environments, allowing bacteria to persist in adverse conditions until favorable conditions return. |
Explore related products
What You'll Learn

Bacterial spores in soil environments
Bacterial spores are not confined to free environments; they thrive notably in soil, where they play pivotal roles in nutrient cycling and ecosystem resilience. Soil, a complex matrix of minerals, organic matter, and microorganisms, provides an ideal habitat for spore-forming bacteria such as *Bacillus* and *Clostridium*. These spores can remain dormant for years, withstanding extreme conditions like desiccation, high temperatures, and chemical stressors, only to germinate when favorable conditions return. This adaptability makes them key players in soil health and fertility.
Consider the process of spore germination in soil, which is triggered by factors like water availability, nutrient presence, and temperature shifts. For instance, *Bacillus subtilis* spores require specific nutrients like amino acids and purine nucleosides to initiate germination. Farmers and gardeners can leverage this knowledge by amending soil with organic matter rich in these compounds to promote beneficial bacterial activity. However, caution is necessary; over-amending can create anaerobic conditions, favoring pathogenic spore-formers like *Clostridium botulinum*. Balancing soil amendments with proper aeration is critical for optimal outcomes.
From a comparative perspective, bacterial spores in soil outcompete their free-living counterparts due to their resilience. While free bacteria are more susceptible to environmental fluctuations, spores act as a reservoir of genetic diversity, ensuring bacterial survival across generations. This is particularly evident in agricultural soils, where tillage and chemical treatments decimate active bacterial populations but leave spores largely unaffected. Over time, these spores germinate and repopulate the soil, maintaining microbial balance. This underscores the importance of preserving spore-rich soils in sustainable farming practices.
Practically, understanding spore dynamics in soil can guide effective land management. For example, crop rotation and reduced tillage encourage spore accumulation, enhancing soil structure and disease suppression. Additionally, bioinoculants containing spore-forming bacteria, such as *Bacillus amyloliquefaciens*, are increasingly used to combat plant pathogens. When applying such products, ensure soil moisture levels are adequate, as spores require hydration to germinate. Dosage typically ranges from 10^6 to 10^8 colony-forming units per gram of soil, depending on the product and target crop.
In conclusion, bacterial spores in soil environments are not merely passive survivors but active contributors to ecosystem stability. Their unique ability to endure harsh conditions and revive under favorable circumstances makes them indispensable in both natural and managed ecosystems. By integrating this knowledge into soil management practices, we can foster healthier, more productive landscapes while minimizing reliance on chemical interventions.
Understanding Moss Spores: Are They Diplohaplontic? A Detailed Look
You may want to see also

Spores in aquatic ecosystems
Bacterial spores are not confined to free-living environments; they thrive in aquatic ecosystems, playing pivotal roles in nutrient cycling and ecosystem resilience. These dormant forms of bacteria are remarkably resilient, surviving extreme conditions such as desiccation, UV radiation, and temperature fluctuations. In aquatic settings, spores act as a seed bank, ensuring bacterial populations can rebound after environmental disturbances. For instance, *Bacillus* and *Clostridium* species are commonly found in sediments, where their spores remain viable for years, waiting for favorable conditions to germinate.
Consider the practical implications of spore presence in water treatment systems. Spores of *Bacillus subtilis* and *Clostridium perfringens* are often used as indicators of water quality, as they can withstand chlorine disinfection. To mitigate their persistence, advanced treatment methods like UV irradiation or ozonation are recommended. For home aquariums or small-scale water systems, maintaining temperatures below 10°C can inhibit spore germination, though this is not a foolproof method. Regular monitoring and targeted treatments are essential to prevent spore-forming bacteria from dominating aquatic environments.
Aquatic spores also exhibit fascinating adaptations to their environments. In marine ecosystems, spores of *Sporosarcina* species have been observed to attach to surfaces, forming biofilms that enhance their survival. This behavior contrasts with freshwater spores, which often remain suspended in the water column. Such differences highlight the importance of context-specific strategies when studying or managing spore populations. For researchers, isolating spores from aquatic samples requires techniques like heat shock (70°C for 10 minutes) to kill vegetative cells while preserving spores for further analysis.
From an ecological perspective, spores contribute to the stability of aquatic ecosystems by serving as a food source for protozoa and other microorganisms. However, their presence can also pose risks, particularly in eutrophic waters where nutrient-rich conditions favor spore germination and bacterial blooms. To balance these dynamics, ecosystem managers should focus on reducing nutrient runoff and promoting biodiversity, which can suppress spore-forming bacteria through competitive exclusion. For instance, introducing algae-grazing organisms can limit the organic matter available for spore germination.
In conclusion, bacterial spores in aquatic ecosystems are not merely passive survivors but active participants in ecological processes. Their unique adaptations and roles demand tailored approaches for both research and management. Whether in natural waters or engineered systems, understanding spores’ behavior is crucial for maintaining water quality and ecosystem health. By integrating specific strategies—from advanced treatment technologies to ecological interventions—we can effectively address the challenges posed by these resilient microbial forms.
Can Bacteria Reproduce by Spores? Unveiling Microbial Survival Strategies
You may want to see also

Role of spores in extreme conditions
Bacterial spores are not confined to free environments; they thrive in extreme conditions where most life forms cannot survive. These dormant structures, produced by certain bacteria like *Bacillus* and *Clostridium*, are remarkably resilient, enduring temperatures exceeding 100°C, desiccation, and exposure to radiation. For instance, spores of *Bacillus subtilis* can survive for decades in soil, waiting for favorable conditions to reactivate. This adaptability allows them to persist in environments ranging from deep-sea hydrothermal vents to the arid surfaces of deserts, challenging the notion that spores are limited to benign settings.
Consider the practical implications of spore survival in extreme conditions. In the food industry, spores of *Clostridium botulinum* can withstand pasteurization temperatures, necessitating more aggressive sterilization methods like autoclaving at 121°C for 15 minutes. Similarly, in healthcare, spores of *Clostridioides difficile* persist on hospital surfaces, resisting standard disinfectants and contributing to nosocomial infections. Understanding spore resistance is critical for developing effective decontamination protocols, such as using hydrogen peroxide vapor or UV-C light, which can penetrate spore coats and inactivate them.
From an evolutionary perspective, spores serve as a survival mechanism, ensuring bacterial continuity in hostile environments. Their multilayered structure, including a thick protein coat and a peptidoglycan cortex, provides mechanical and chemical protection. For example, spores of *Deinococcus radiodurans* can withstand radiation doses up to 5,000 Gy, far exceeding the lethal limit for humans (4 Gy). This resilience is attributed to efficient DNA repair mechanisms, which spores activate upon germination. Such adaptations highlight the role of spores as biological time capsules, preserving genetic material until conditions improve.
To combat spore-forming pathogens in extreme settings, targeted strategies are essential. In space exploration, where spores can contaminate extraterrestrial environments, NASA employs rigorous sterilization techniques, including dry heat treatment at 110°C for 40 hours. In agriculture, crop rotation and soil solarization (heating soil to 50–60°C) reduce spore populations, minimizing diseases like *Bacillus cereus* wilt. For individuals handling spore-contaminated materials, wearing PPE and using spore-specific disinfectants like chlorine dioxide (500 ppm) are recommended. These measures underscore the importance of tailoring interventions to the unique challenges posed by spores in extreme conditions.
In summary, bacterial spores defy environmental constraints, playing a pivotal role in extreme conditions by ensuring bacterial survival and persistence. Their ability to endure heat, radiation, and desiccation necessitates specialized strategies for control and eradication. Whether in food safety, healthcare, or space exploration, understanding spore biology is key to mitigating risks and harnessing their potential. By studying their mechanisms of resistance, we can develop innovative solutions to combat spore-related challenges across diverse fields.
Buying Magic Mushroom Spores in California: Legal or Not?
You may want to see also
Explore related products

Spores inside host organisms
Bacterial spores are often associated with their ability to survive in harsh, free-living environments, but their presence and behavior inside host organisms reveal a more complex and strategic survival mechanism. Unlike their dormant state in soil or water, spores within a host can exhibit unique interactions, influenced by the host's immune system, nutrient availability, and environmental cues. This internal environment challenges the notion that spores are merely passive entities waiting for optimal external conditions to germinate.
Consider the case of *Bacillus anthracis*, the causative agent of anthrax. Its spores can remain dormant inside a host for extended periods, only germinating when conditions become favorable, such as in macrophages or nutrient-rich tissues. This strategic germination is not random but triggered by specific host factors like temperature, pH, and nutrient availability. For instance, spores of *B. anthracis* are known to germinate at body temperature (37°C) and in the presence of amino acids like L-alanine, which are abundant in host tissues. This highlights how spores adapt their survival strategies to exploit the host environment.
From a practical standpoint, understanding spore behavior inside hosts is crucial for medical interventions. For example, in treating anthrax, antibiotics like ciprofloxacin or doxycycline are administered at dosages of 500 mg every 12 hours for adults, targeting both vegetative bacteria and preventing spore germination. However, the timing of treatment is critical; spores that have already germinated are more susceptible to antibiotics, emphasizing the need for early detection and intervention. This underscores the importance of recognizing spores not just as external threats but as dynamic entities within the host.
Comparatively, *Clostridioides difficile* spores demonstrate a different interaction within the human gut. These spores can resist stomach acid and germinate in the colon, where bile salts act as triggers. This process is influenced by the host’s microbiome composition, with dysbiosis often facilitating spore germination. For instance, a disrupted gut microbiome due to antibiotic use can reduce competitive bacteria, allowing *C. difficile* spores to thrive. Probiotic supplementation, such as *Lactobacillus* strains, can help restore balance and inhibit spore germination, offering a preventive strategy for vulnerable populations like the elderly or immunocompromised individuals.
In conclusion, bacterial spores inside host organisms are not merely dormant entities but active participants in a complex interplay with their environment. Their ability to sense and respond to host-specific cues challenges the notion of spores as solely free-living survivors. By understanding these interactions, we can develop targeted interventions, from antibiotic regimens to microbiome modulation, to combat spore-associated infections more effectively. This perspective shifts the focus from external spore management to internal spore dynamics, offering a more nuanced approach to bacterial spore research and treatment.
Tetanus Spores and Ozone Resistance: Uncovering the Truth
You may want to see also

Human-made environments hosting spores
Bacterial spores are not confined to natural, free environments; they thrive in human-made settings, often with surprising resilience. From hospital wards to food processing plants, these dormant survival structures exploit the very environments humans create, posing challenges in sanitation and health. Understanding their presence in these spaces is critical for effective control and prevention strategies.
Consider healthcare facilities, where cleanliness is paramount. Despite rigorous sterilization protocols, bacterial spores, particularly *Clostridioides difficile* and *Bacillus* species, persist on surfaces like bed rails, doorknobs, and medical equipment. A study in *Infection Control & Hospital Epidemiology* found that *C. difficile* spores can survive for up to five months on dry surfaces, highlighting the need for spore-specific disinfectants like chlorine-based cleaners (1,000–5,000 ppm sodium hypochlorite). For high-touch areas, implement a two-step process: clean with soap and water, then disinfect with a spore-killing agent, ensuring contact time of at least 10 minutes.
In food production, bacterial spores are a persistent threat. *Bacillus cereus* and *Clostridium perfringens* spores survive heat treatments, contaminating canned foods, dairy products, and even spices. For instance, low-acid canned goods require retorting at 121°C (250°F) for 3 minutes to ensure spore destruction. Home canners should follow USDA guidelines, using pressure canners for low-acid foods and boiling water canners for high-acid foods like jams. Always verify processing times based on altitude and container size to prevent spore survival.
Even water distribution systems, designed to deliver clean water, can harbor spores. *Mycobacterium* and *Legionella* spores colonize biofilms in pipes, especially in stagnant water. Regular flushing of unused lines and maintaining temperatures above 60°C (140°F) in hot water systems can mitigate risk. For households, run taps weekly in infrequently used areas and consider installing point-of-use filters with 0.2-micron pore size to trap spores.
Finally, consider the built environment itself. HVAC systems, carpet fibers, and insulation materials can trap spores, recirculating them indoors. A study in *Indoor Air* revealed that *Aspergillus* and *Penicillium* spores accumulate in air filters, particularly in humid climates. To minimize exposure, replace HVAC filters every 1–3 months, maintain indoor humidity below 50%, and vacuum carpets weekly with HEPA-filtered devices. For mold-prone areas, use fungicidal coatings on walls and ceilings, reapplying annually.
By recognizing these human-made environments as spore reservoirs, targeted interventions can disrupt their lifecycle. Whether in healthcare, food production, water systems, or buildings, combining scientific knowledge with practical measures ensures safer, spore-free spaces.
Can Moldy Food Spores Trigger Respiratory Infections? Uncover the Truth
You may want to see also
Frequently asked questions
No, bacterial spores can exist both in free environments (such as soil, water, and air) and within the host organism or on surfaces.
Yes, bacterial spores can survive inside living organisms, such as in the gastrointestinal tract, without necessarily causing immediate infection until conditions become favorable for germination.
Bacterial spores are not exclusive to natural environments; they can also be found in controlled settings like laboratories, hospitals, and food processing facilities due to their resilience and ability to persist on surfaces.
Bacterial spores typically form in response to environmental stresses, such as nutrient depletion, and usually develop outside of a host. However, some spore-forming bacteria can sporulate within a host under specific conditions.

























